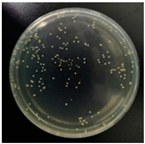
Molecules 29 04286 i001
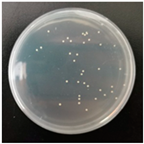
Molecules 29 04286 i003
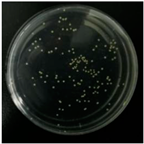
Molecules 29 04286 i004
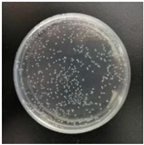
Molecules 29 04286 i005

Abstract
In this paper, a series of tetrameric surfactants (4CnSAZs, n = 12, 14, 16) endowed with zwitterionic characteristic were synthesized by a simple and convenient method and their structures were characterized by FT-IR, 1H NMR and elemental analysis. Their physicochemical properties were studied using the Wilhelmy plate method, fluorescence spectra and dynamic light scattering technique. 4CnSAZs have higher surface activities and tend to adsorb at the air/water surface rather than self-assembling in aqueous solution. The thermodynamic parameters obtained from surface tension measurements show that both processes of adsorption and micellization of 4CnSAZs are spontaneous and that the micellization processes of 4CnSAZs are entropy-driven processes. Both adsorption and micellization of 4CnSAZs are inclined to occur with the increase of alkyl chain length or temperature. For 4C12SAZs, there are only small-size aggregates (micelles), while the large aggregates (vesicles) are observed at the alkyl length of 4CnSAZs of 14 or 16. This shows that the alkyl chain length for oligomeric surfactants has a greater sensitivity for aggregate growth. The aggregate morphologies obtained from the calculated values of critical packing parameter (p) for 4C14SAZs and 4C16SAZs can be supported by the DLS measurement results. The test results obtained by the separation-water-time method show that 4CnSAZs have good emulsification performance and that the prepared emulsions appear to exit in the form of multiple emulsions. In addition, 4CnSAZs have good antibacterial activities against Escherichia coli (E. coli) and Staphylococcus aureus (S. aureus). The present study reveals the unique behavior of a zwitterionic tetrameric surfactant and may give new insights into molecular design and synthesis of a high degree of surfactants with different structure characteristics for potential application in various industrial fields.
1. Introduction
Zwitterionic surfactants are amphiphilic molecules, in which their two polar groups (basic and acidic groups) that exhibit amphoteric characters are connected through a spacer group [1,2]. Zwitterionic surfactants contain no counterions, and conversely, molecules bear a balance of positively and negatively charged functional groups in a similar way as many amino acids [3,4]. They have a lot of superior properties such as good water solubility, salt resistance, high-temperature resistance, and good synergistic effect, as compared with other ionic surfactants [5,6]. These inherent features make them gain considerable attention, both in the academic field and industrial applications [7]. At present, there are many different zwitterionic surfactants synthesized and the demand for this kind of surfactant is increasing each year [8].
Gemini surfactants, also called dimeric surfactants, consist of two polar head groups and two hydrophobic groups covalently connected by spacer groups [9,10], and were known as a new generation of surfactants in the 1990s [4]. Because the kind of surfactants exhibits unique physicochemical properties such as lower critical aggregation concentration (CAC), higher efficiency to reduce surface tension, and greater wettability and emulsifiability as compared with the conventional monomeric surfactants, they have become one of the research focuses in the colloid and interface chemistry [11,12,13,14].
Over the past few decades, more research in the area has focused on the synthesis of different structures of gemini surfactants such as heteroatoms [15,16] or zwitterionic structures [17,18] and their physicochemical properties. So far, a more systematic research is the structure-effective relationship of linear gemini surfactants because of their simple synthesis methods. For zwitterionic gemini surfactants containing two different charged ionic or nonionic groups as hydrophilic moieties, there is a smaller electrostatic repulsion between the hydrophilic head groups of the same molecule or different molecules, and this helps improve a compact arrangement at the interface and greatly reduces surface tensions [19,20]. The existence of zwitterions in the same molecule makes them have a unique aggregation morphology and unique rheology in aqueous solution, which makes them increase more potential applications. Zhou [21] and Cheng [22] independently reviewed the developments of zwitterionic gemini surfactants in sequence until 2019. Xu et al. [23] reported the synthesis of a novel trimeric octadecyl zwitterionic surfactant (TOCC), and its three branched chains contain six quaternary ammonium atoms and three carboxylate groups. The unique structure of TOCC enriches the variety of trimeric surfactants and results in the electropositivity of TOCC. Park et al. [24] synthesized an eco-friendly phospholipid-based zwitterionic gemini surfactant (CDP-W) with coconut oil source, and CDP-W molecules have two quaternary ammonium atoms and a phosphate group. CDP-W with superior antiseptic and antiviral performances can replace cocamidopropyl betaine in the formulation of cosmetics, personal products and household products.
To meet the increasing needs of industry and life in lots of aspects for surfactants and excellent properties of dimeric surfactants, researchers are stimulated to synthesize surfactants with three or more hydrophobic and hydrophilic groups and study their basic physicochemical properties. This kind of surfactants is again referred to as oligomeric surfactants, such as trimeric or tetrameric surfactants. According to spacer structures, oligomeric surfactants may be divided into three main types, line-type, star-type and ring-type, while the reports on the ring-type are relatively few [25,26]. Most of the pioneering works on synthesis, self-assembly and rheological properties of linear oligomeric surfactants, referred as as the natural extension of Gemini surfactants in one dimension, have been done by Zana et al. [27,28,29]. There are more spacer groups in a molecule, which makes the synergistic effect between multiple alkyl chains stronger and the electrostatic repulsion among charged headgroups smaller. Thus, as compared with single-chain and gemini surfactants, the linear oligomeric surfactants are more inclined to adsorb at the interface or form abundant aggregate structures in water solution. The star-shaped oligomeric surfactants display symmetric or dissymmetric dendritic configurations and branched three-dimensional structures. Their spacer groups derive from a central moiety such as an atom or a group of atoms, and the polar head groups are covalently linked with hydrophobic chains or planar aromatic groups [30]. The special structures of such surfactants may overcome the rigidity of the spacer groups, decrease intermolecular electrostatic repulsion, and enhance the hydrophobic association among alkyl chains of the same or different molecules.
Menger et al. [31] synthesized three series of star-shaped cationic oligomeric surfactants with pentaerythritol (PE), dipentaerythritol (DPE), and adamantane (AD) as a core, and only solubility and aggregate behavior were studied. Marangoni et al. [32,33,34] also reported the synthesis of five series of cationic, three series of anionic, and zwitterionic gemini surfactants from pentaerythritol. In addition, a family of three-headed five-tailed oligomeric surfactants were also synthesized with tripentaerythritol as a backbone. The synthesis routes of all the above surfactants are complex, and some of the reagents and catalysts are unstable and toxic. Asadov et al. [35] synthesized a nonionic oligomeric surfactant by oxypropylation reaction via pentaerythritol and propylene oxide with an alkali catalyst, and this product has the inhibition ability of gasoline evaporation, and good industrial prospect because of relatively low cost and availability of raw materials. Abdel-Raouf [36] carried out etherification by polyethylene glycol and pentaerythritol, and then the intermediate reacted with fatty acid and obtained biodegradable tetrameric star-shaped surfactants. These surfactants may act as oil spill dispersants and have a characteristic of mature production technology.
In this study, a series of zwitterionic tetrameric surfactants (4CnSAZs) were prepared just by sulfating four hydroxyl groups of 4CntetraQs synthesized in our previous work [37]. The reaction routes include three cheap, mild reactions, and they are etherification after ring opening for epichlorohydrin, quaterization for trialkylamine, and sulfation of hydroxyl groups. All these unit operations are mature technologies and have the advantages of wide raw material sources, convenient treatment, and simple production. The process combination of three common cheap reactions may make the difficult synthesis of the oligomeric surfactants with complex structures become easier. The physicochemical properties of 4CnSAZs were studied by the Wilhelmy plate method, fluorescence spectra and dynamic light scattering technique. The emulsification properties of 4CnSAZs were investigated by separation-water-time method and micrography. The antibacterial activities of 4CnSAZs against E. coli and S. aureus were performed by plate count method.
2. Results and Discussion
2.1. Structural Characterization
The structures of 4CnSAZs were characterized by 1H NMR, FT-IR and elemental analysis. The characteristic results for FT-IR and 1H NMR are given in Figure 1, Figure 2 and Figure 3, in which the integration curve of 1H NMR for 4C14SAZ is shown in Figure 3 as an example.
Figure 1.
Infrared spectrum of zwitterionic tetrameric surfactants (4CnSAZs, n = 12, 14, 16).
Figure 2.
1H NMR spectra of zwitterionic tetrameric surfactants (4CnSAZs, n = 12, 14, 16).
Figure 3.
Integrated curve of 4C14SAZ nuclear magnetic resonance hydrogen spectrum.
4C12SAZ: FT-IR (KBr), 2921.50, 2850.72 cm−1 (C–H stretching); 1473.18, 1462.29 cm−1 (C–H bending in-plane); 1217.99 cm−1 (–SO3– stretching); 1104.88 cm−1 (C–O–C stretching); 1043.47 cm−1 (C–N+ stretching); 718.94 cm−1 (–CH2– stretching). 1H NMR (600 MHz, CDCl3, ppm), δ: 0.79 (t, 12H, CH3–CH2); 1.16 (m, 80H, CH3–(CH2)10); 1.74 (s, 8H, CH3–(CH2)10–CH2); 2.75 (d, 24H, CH3–N+–CH3); 2.92 (m, 8H, CH2–N+); 3.94 (t, 4H, CH–O–SO3H); 4.02 (q, 16H, O–CH2); 11.97 (s, 4H, O–SO3–H). Anal. Calcd. for C73H156O20S4N4 %: C, 57.0; H, 10.22; N, 3.64. Found %: C, 56.88; H, 10.28; N, 3.59.
4C14SAZ: FT-IR (KBr), 2921.42, 2850.61 cm−1 (C–H stretching); 1473.30, 1462.54 cm−1 (C–H bending in–plane); 1210.31 cm−1 (–SO3– stretching); 1105.50 cm−1(C–O–C stretching); 1060.85 cm−1 (C–N+ stretching); 719.11 cm−1 (–CH2– stretching). 1H NMR (600 MHz, CDCl3, ppm), δ: 0.81 (t, 12H, CH3–CH2); 1.18 (m, 96H, CH3–(CH2)12); 1.76 (m, 8H, CH3–(CH2)12–CH2); 2.78 (s, 24H, CH3–N+–CH3); 2.95 (m, 8H, CH2–N+); 3.96 (t, 4H, CH–O–SO3H); 4.05 (q, 16H, O–CH2); 11.65 (s, 4H, O–SO3–H). Anal. Calcd. for C81H172O20S4N4 %: C, 58.95; H, 10.5; N, 3.39. Found %: C, 58.81; H, 10.55; N, 3.35.
4C16SAZ: FT-IR (KBr), 2919.65, 2849.81 cm−1 (C–H stretching); 1472.75, 1463.20 cm−1 (C–H bending in–plane); 1222.61 cm−1 (–SO3– stretching); 1111.59 cm−1 (C–O–C stretching); 1065.33 cm−1 (C–N+ stretching); 719.77 cm−1 (–CH2– stretching). 1H NMR (600 MHz, CDCl3, ppm), δ: 0.81 (t, 12H, CH3–CH2); 1.18 (m, 96H, CH3–(CH2)12); 1.76 (m, 8H, CH3–(CH2)12–CH2); 2.78 (s, 24H, CH3–N+–CH3); 2.95 (m, 8H, CH2–N+); 3.96 (t, 4H, CH–O–SO3H); 4.05 (q, 16H, O–CH2); 11.65 (s, 4H, O–SO3–H). Anal. Calcd. for C89H188O20S4N4 %: C, 60.64; H, 10.75; N, 3.18. Found %: C, 60.56; H, 10.82; N, 3.11.
2.2. Surface Activity
The surface tension measurement is a classical method of studying the critical aggregation concentration (CAC) of surfactants. The results of surface tension measurements for 4CnSAZs (n = 12, 14, 16) aqueous solutions were shown in Figure 4 at different temperatures, and the CAC and the surface tension at CAC (γCAC) were given in Table 1.
Figure 4.
The curves of surface tension versus log concentration of 4CnSAZs at different temperature: (a) 4C12SAZ, (b) 4C14SAZ, (c) 4C16SAZ.
Table 1.
Physicochemical parameters of the different surfactants.
As expected, zwitterionic tetrameric 4CnSAZs display remarkable physicochemical properties such as lower CAC and greater efficacy in lowering surface tension. For example, the CAC and the corresponding γCAC for 4C12SAZ at 25 °C are 0.236 mmol L−1 and 26.10 mN/m, respectively, are much lower than those of conventional ionic surfactants, for example, sodium dodecyl sulfonate (SDS, 7.25 mmol L−1, 34.8 mN/m) [38,39] and dodecanaminium bromide (DTAB, 15.7 mmol L−1, 38.9 mN/m) [40,41]. This implies that 4CnSAZs have excellent micelle-forming ability and the ability to reduce surface tension at low concentrations. 4CnSAZs have four alkyl chains closely connected in the single molecule, and the whole molecule is electrically neutral. This structure characteristic of 4CnSAZs can enhance the hydrophobic association among alkyl chains of the same or different molecules and decrease intermolecular electrostatic repulsion, which can result in more compact arrangement of 4CnSAZs molecules at the air-water interface. The longer the alkyl chain length of 4CnSAZs becomes, the lower the values of CAC and γCAC are [42]. These results may be accounted for by the fact that the hydrophobicity of the surfactant will increase with increasing length of the alkyl tail chain. The strong hydrophobic effect can destroy the water structure and increase the free energy of the system, which triggers the directed migration of surfactant molecules to the gas/liquid interface or aggregation into a micellar structure [43].
This behavior, in turn, results in the relaxation in the free energy of surfactant solution, consequently inducing a decrease in the CAC and γCAC. In addition, as the temperature increases, the CAC and corresponding γCAC of 4CnSAZs decreases. The decrease of CAC may be due to the reduction of the water hydration degree of polar head groups that can help promote micellization. Moreover, the increase of solution temperature can break hydrogen bonding between water molecules and polar head groups and make head groups decrease their hydrophilicity [44]. The hydrophilicity reduction of head groups can promote surfactant molecules to escape from the water phase and closely adsorb at the air/water interface, resulting in lower surface tension. This is probably because the increasing temperature accelerates the thermal motion of surfactant molecules and weakens the electrostatic interaction between the head groups of surfactant molecules [45].
The surface adsorption parameters including maximum surface excess concentration (Γmax) and the area minimum (Amin) were calculated with the Gibbs adsorption isotherm Equations (1) and (2) [46].
where R is the gas constant (8.314 J mol−1 K−1); T is the thermodynamic temperature (K); n is a constant, and its value depends on the type of composition adsorbed at the air/water interface. The zwitterionic surfactant is an internal salt and the whole molecule is electrically neutral. Thus, the value of n is 1 [47,48]; (dγ/dlogC) is the slope below the CAC in the surface-tension plots; NA is the Avogadro’s number (6.02 × 1023). The Γmax may indicate the amount of accumulated 4CnSAZs molecules in the interface, and Amin can reflect the tightness of the arrangement of surfaceactive molecules in the interface, with smaller values indicating a tighter arrangement.
The Amin values for 4CnSAZs are far smaller than those of the traditional single-chain surfactant, which indicate that 4CnSAZs can adsorb efficiently and pack tightly at the gas/water interface, forming a coherent interface film [49]. In turn, this also helps to explain that 4CnSAZs have an extremely low CAC. The neutralization of the same amount of positive and negative charges in the same molecule and the electrostatic attraction between the opposite charges of different molecules are also helpful for a tight package [8]. It is found that an increase in the hydrocarbon tail length from 12 to 16 may lead to an increase in Γmax and a decrease in Amin, in which these results are in accordance with the outcomes reported in other literature [50]. This is due to the increase of molecular structure complexity, steric hindrance of the alkyl chain, hydrophobic interaction force, and the decrease of hydrophilic-lipophilic equilibrium value (HLB). In addition, 4CnSAZs molecules were oriented horizontally, which may decrease the amount of the accumulated 4CnSAZs molecules at the interface [49].
Two significant parameters of investigated amphiphiles, i.e., the effectiveness of surface tension lowering (πCAC) and the adsorption efficiency (pC20), were determined from surface tension isotherms with the following Equations (3) and (4) [51].
where γCAC and γ0 are the surface tension of surfactant solution at CAC and pure water, respectively; C20 is the concentration of surfactant required to produce a 20 mN/m reduction in surface tension.
πCAC represents the effectiveness of amphiphilic molecules to maximal lower the surface tension of water. Therefore, πCAC is used as a metric to assess the maximum reduction of surface tension [51,52]. Specifically, high values of πCAC refer to the formation of a compact layer at the interface, whereas low values indicate loose packing of surfactant molecules at the interface [43]. The outcomes from Table 1 show that the πCAC increases with the increase of hydrophobic chain length.
pC20 represents the efficiency of surfactants in reducing water surface tension. The larger the pC20, the higher its efficiency in reducing water surface tension, and the less amount required in practical applications. As can be seen from Table 1 that pC20 values for 4CnSAZs are two or more higher than those of the conventional ionic surfactants, such as SDS and CTAB, and this means that zwitterionic 4CnSAZs molecules are inclined to adsorption at the gas/liquid interface than those of the analogue ionic unimers.
2.3. Thermodynamics of Micellization/Thermodynamic Parameters
The thermodynamic parameters of the synthesized zwitterionic tetrameric surfactants at 25 °C, 35 °C, 45 °C, and 55 °C were calculated using the Gibbs Equations (5)–(8) [53,54], and are summarized in Table 2.
where R is the gas constant, 8.314 J mol−1 K−1 and T is the absolute temperature; ΔGomic and ΔGoads are the standard Gibbs free energy changes of micellization and adsorption, respectively; ΔHomic is the standard enthalpy change of the micellization; ΔSomic is the standard entropy of micelle formation.
Table 2.
Thermodynamic parameters in the micellization and adsorption processes for 4CnSAZs.
As can be seen from Table 2 that all values of ΔGomic and ΔGoads are negative, indicating that the micellization and adsorption of these surfactants are all spontaneous [55]. In this case, ΔGoads is more negative than the corresponding ΔGomic, showing that adsorption is the primary process compared to micellization [53]. As temperature increases, the absolute values of ΔGomic and ΔGoads increase gradually. Thus, increasing temperature favors both micellization and adsorption of surfactant molecules. At the same time, the increase of alkyl chain length from 12 to 16 has the same impact as increasing temperature. The absolute values of ΔGoads are slightly bigger than those of ΔGomic, showing that surfactant molecules have a big tendency to adsorb at the interface rather than form micelles [56].
All positive ΔSomic values indicate that the micellizations are the entropy-driven process. The increase of the disorder degree of the system may be attributable to the destruction/collapse of the “ice structure” consisting of water molecules around hydrophilic groups, whereas the aggregation process of surfactant molecules results in the decrease of the disorder degree of the system. In addition, the instability of the iceberg structure can also entice an increase in positive ΔSomic. The increasing temperature will enhance the disorder degree of water molecules, which results in the increase of ΔSomic [57].
As shown in Table 2, ΔHomic are positive, indicating that both micellization and adsorption processes are controlled by the entropy change, and both processes are endothermic. The values of −TΔSomic are far smaller than those of ΔHomic, showing that micellization processes of surfactant molecules are controlled by entropy.
2.4. Micropolarity
As is well known that the micellization behavior of surfactants in an aqueous solution is obtained from a steady-state fluorescence spectrum with pyrene as a probe, in which the intensity ratio between the first and third vibrational peaks (I1/I3) in the fluorescence spectrum may be used to characterize the polarity of the probe’s microenvironment. The decrease in the I1/I3 ratio means that pyrene molecules are migrating from a polar region to a nonpolar region (aggregates).
Figure 5 shows variations of the pyrene polarity ratio (I1/I3) vs. 4CnSAZs concentration at 25 °C. As can be seen in Figure 5, the I1/I3 ratio changes sharply at the concentrations around the CAC, showing that a small number of aggregates begin to form and solubilize pyrene in the inner hydrophobic region of aggregates [57]. The minimum ratio of I1/I3 decreases with the increase of alkyl chain length, suggesting that the strong hydrophobic interaction among longer alkyl tails can make the palisade layer arrange more tightly and result in a reduction in polarity [55].
Figure 5.
Variation of the pyrene fluorescence intensity ratio (I1/I3) vs. 4CnSAZs concentration at 25 °C.
2.5. Critical Arrangement Parameters and Aggregate Morphology
The critical packing parameter (P) [55] is used to better reflect the geometric morphology of aggregates by the association of 4CnSAZs molecules in water, and may be calculated by the Equations (9)–(12) [58,59].
where, a0 is the average parking area of the polar head group in a surfactant molecule. Vhydrophobic and l0 are the volume and length of an alkyl chain, respectively. Moreover, m is the number of carbon atoms in an alkyl chain.
The shape and geometry of the aggregates can be predicted according to the p values as shown in Table 3. According to the theory of critical packing parameter, when p values range from 0 to 0.33, the spherical micelles are inclined to form in the surfactant solution. The p values are from 0.33 to 0.5, for nonspherical micelles. It is 0.5 to 1, for bilayers or vesicles. As can be seen from Table 3, the p value of 4C12SAZ is 0.46, and this means that 4C12SAZ molecules may form nonspherical micelles in an aqueous solution. However, p values for 4C14SAZ and 4C16SAZ are above 0.5, showing that such surfactants with longer alkyl chains may form vesicle structures and this also is in accordance with the DLS results. The formation of bigger aggregates when n ≥ 14 may be caused by the stronger hydrophobicity imparted by the four longer hydrocarbon chains [42].
Table 3.
The Critical arrangement parameters of 4CnSAZs.
To study the arrangement of the alkyl chains of surfactant molecules in the vesicular region, the radius values of aggregates can be calculated by Tanford’s equation. As can be seen from Table 3, the R values are above twice the length of the hydrophobic chain fully extended, which means that the bilayer thickness of vesicles for 4C14SAZ and 4C16SAZ is above twice the hydrophobic chain length [58]. The alkyl chains of tetrameric surfactant molecules forming vesicle structures may present a face-to-face attitude and parallel arrangement. The possible aggregate model is given in Figure 6.
Figure 6.
The possible aggregate model of 4C14SAZ and 4C16SAZ in the aqueous solution.
2.6. DLS
The DLS is one of the strongest tools used to determine the size distribution and speculate the shapes of various aggregates formed in the aqueous solution.
As shown in Figure 7, when 4CnSAZs (n = 12, 14) concentration is 2 CAC, there are the small spherical micelles observed in all 4CnSAZs solutions. For 4C12SAZ, when its concentration ranges from 2 CAC to 10 CAC, there are only small size aggregates (1.6 nm) observed. These results are not in accordance with the results from the p value calculated, which may be due to the fact that the calculated value of average parking area (a0) of polar head groups of 4C12SAZ is smaller than its practical value. For 4C14SAZ, when its concentration is 10 CAC, the big aggregates (100–185 nm) may be observed. While the alkyl length increases to 16, aggregates of both small sizes and large ones can be observed at each concentration investigated, and the latter usually is assigned to the vesicle. The above results suggest that the alkyl chain length has a greater sensitivity for aggregate growth than the sizes of concentration [60]. These test results are in accordance with the hydrodynamic sizes of aggregates of gemini (G-12, G-14, G-16) reported in the literature [1]. In Figure 7b,c, there exist larger Rh and smaller Rh, which means that vesicles coexist with small micelles [61]. In addition, there are three peaks in which Rh is smaller than 1 nm for 4C14SAZ and C16SAZ. These peaks are not assigned to micelles and may be induced by the unique structure of oligomeric surfactants with multipolar head groups [62,63].
Figure 7.
The aggregate hydrodynamic radius (Rh) of 4CnSAZs: (a) 4C12SAZ, (b) 4C14SAZ, (c) 4C16SAZ.
2.7. Antibacterial Performance
The antibacterial activities of 4CnSAZs were tested against two different microorganisms (E. coli and S. aureus) at 4CnSAZs concentration of 0.5 g/L, and the evaluation results are shown in Table 4 and Figure 8. As can be seen from Table 4, 4CnSAZs exhibit good antimicrobial activities, and this is attributable to the fact that there are four N+ groups and four alkyl chains in the zwitterionic tetrameric surfactants that may facilitate more electrostatic and hydrophobic interactions with the cell membrane, which increases the permeability of the cell membranes and leads to the leakage of cell contents and the disturbance metabolisms of microorganisms [64]. The antibacterial rates decrease with the increase of alkyl chain length, suggesting that there exists a distinct relationship between structure and antimicrobial activities for 4CnSAZs. The optimum length of the alkyl chain for 4CnSAZs is 12. That is, 4C12SAZ has the best antimicrobial activity among 4CnSAZs. The increasing of the alkyl chain length of 4CnSAZs will strengthen their hydrophobic character and decrease water solubility, which may be also supported by the lower CAC for surfactants with longer alkyl. These test results are in accordance with the antibacterial effect of other oligomeric surfactants reported in the literature [48].
Table 4.
Antibacterial activities of synthesized 4CnSAZs at the concentration of 0.5 g/L against bacteria (E. coli and S. aureus) by plate count method.
Figure 8.
The antibacterial rates of synthesized 4CnSAZs against bacteria (E. coli. and S. aureus).
Although it is wished that a compound has similar bactericidal effect on Gram-positive and Gram-negative bacteria, it is not always the case for different bacterial strains. As shown in Table 4 and Figure 8, 4CnSAZs show higher activities against Gram-positive bacteria (S. aureus) than Gram-negative bacteria (E. coli), which is due to the cell wall of S. aureus that is more permeable and disturbed than E. coli. According to literature data [65,66], the cell wall of S. aureus is very simple, and mainly composed of a mesh-like structure, while E. coli has a more complex cell wall that contains a layer of peptidoglycan between the cytoplasmic membrane and an outer membrane that includes lipopolysaccharides cross-linked by divalent cations. The above complex structure helps to maintain the outer membrane stable and makes lipophilic molecules more difficult in permeating into cell wall.
2.8. Emulsification Performance
Emulsification is one of the most important surface properties of surfactants at the application field, and emulsion stability is mainly dependent on the ability of surfactants to reduce surface tension and the mechanical strength of the interface film formed in the emulsion [67].
The emulsification performance of 4CnSAZs was studied at different concentrations at 298.15 K, and is shown in Table 5, and the microscopic morphology of the emulsion is given in Figure 9. It can be shown that the emulsification of 4CnSAZs is better than the conventional surfactant that has the same alkyl chain length such as CTAB and SDS. This may be because there are four alkyl chains and four polar head groups in the same molecule and the whole molecule is electrically neutral. The Amin value of the single alkyl chain in a 4CnSAZs molecule is less than that of Amin of the traditional single-chain surfactant molecule. This means that 4CnSAZs molecules arrange more tightly in the interface film, and thus enhance the mechanical strength of the interfacial film formed. The emulsion stability increases with the increase of the alkyl chain length, and this conclusion is attributed to a strong hydrophobic effect among the long alkyl chains [68].
Table 5.
Emulsification stability of the 4CnSAZs at room temperature.
Figure 9.
Microscopic photos of 4CnSAZs emulsion by emulsified kerosene at different concentrations: 4C12SAZ: (a1) 0.1 mmol L−1, (a2) 1 mmol L−1, (a3) 10 mmol L−1; 4C14SAZ: (b1) 0.1 mmol L−1, (b2) 1 mmol L−1, (b3) 10 mmol L−1, 4C16SAZ: (c1) 0.1 mmol L−1, (c2) 1 mmol L−1, (c3) 10 mmol L−1.
The emulsification properties of surfactants can be reflected in the size of the emulsion droplets, and the smaller droplets and the narrower droplet size distribution demonstrate that surfactants have high emulsification capability and emulsion stability [69]. As can be seen from Figure 9, the droplet size and the droplet size distribution are smaller and narrower with the increase of the alkyl chain length and concentration for 4CnSAZs, respectively. In addition, from the microscopic images, it is interesting to note that the 4CnSAZs emulsion exists in the form of multiple emulsions. This may be caused by the following factors: First, the four alkyl chains in the same molecule are connected by chemical bonds and thus the alkyl chain space is less influenced by electrostatic repulsion than that of conventional ionic surfactants. Second, the decrease of electrostatic repulsion among different 4CnSAZs and electrostatic attraction between two head groups with opposite charges in the single molecule may be inclined to make alkyl chains arranged more packly in the interface [70]. Third, the 12 strong hydrophilic groups including N+, –OSO3−, –O– in the same molecule may retain a lot of water molecules. The above factors all favor enhancing the mechanical strength and viscosity of the interface film and reducing the formed droplet coalescence [71].
3. Experimental Methods and Materials
3.1. Materials
Pentaerythritol (analytical grade, Tianjin Zhiyuan Chemical Reagent Co., Ltd., Tianjin, China); Potassium hydroxide (analytical grade, Shanghai McLean Biochemical Technology Co., Ltd., Shanghai, China); Dimethyl sulfoxide, epichlorohydrin, dichloromethane, hydrochloric acid, anhydrous ethanol, ethyl acetate, sodium hydroxide (analytical grade, Tianjin Damao Chemical Reagent Factory, Tianjin, China); N,N-Dimethyldodecylamine, N,N-Dimethyltetradecylamine, N,N-Dimethylhexadecylamine (90%, Tixiai Chemical Industry Development Co., Ltd., Shanghai, China); Acetone (analytical grade, Tianjin Dongfang Chemical Plant, Tianjin, China), Trichloromethane (analytical grade, Shanghai Chemical Reagent Factory, Shanghai, China); Chlorosulfonic acid, Sodium dodecyl sulfate (SDS), Cetyl trimethyl ammonium bromide (CTAB) (analytical grade, Shanghai Aladdin Biochemical Technology Co., Ltd., Shanghai, China).
3.2. Synthesis of Zwitterionic Tetrameric Surfactants
3.2.1. Synthesis of Pentaerythritol Tetraglycidyl Ether (I)
Pentaerythritol tetraglycidyl ether was prepared by a cheap etherification after open ring of ECH and alkanol under alkaline catalyst. Dimethyl sulfoxide (70 mL), pentaerythritol (0.033 mol), and potassium hydroxide (0.17 mol) were added to the 250-mL three-necked flask, and then stirred until all the solid materials were dissolved. Epichlorohydrin (0.165 mol) was slowly dropped into the flask at room temperature, and the reaction mixture was heated to 50 °C and maintained for 8 h. After reaction, the mixture was filtered, and the filter cake was washed with dichloromethane. The resulting filtrate is distilled under reduced pressure to get the pale-yellow oily liquid (the intermediate I)
3.2.2. Synthesis of Quaternary Ammonium Tetrameric Surfactant (II)
This is a common quaterization with epoxy groups and alkyl dimethylamines. The intermediate I (0.02 mol) and alkyl dimethylamine (0.1 mol) were added to an ethanol solution (50 mL) containing hydrochloric acid (0.1 mol), and the reaction mixture was refluxed for 48 h. Then, ethanol in the mixture was removed by rotary evaporation to obtain a pale yellow viscous solid. The solid was recrystallized with acetone three times, followed by vacuum drying to obtain a white solid power (the intermediate II).
3.2.3. Synthesis of Zwitterionic Tetrameric Surfactants (4CnSAZs)
The synthesis of 4CnSAZs was carried out by mature sulfation processes of hydroxy groups. First, the intermediate II (0.01 mol) and trichloromethane (30 mL) were added to the 250-mL three-necked flask. Trichloromethane (20 mL) containing chlorosulfonic acid (0.044 mol) was dropped into the reaction flask at the ice bath under stirring. After 6 h, the reaction solution was adjusted to ca. pH 10 by sodium hydroxide alcohol solution (20 wt%). The mixed solution was filtered to remove inorganic salts, and the filtrate was distilled by rotary evaporation to remove trichloromethane and alcohol. The resulting solid was recrystallized with ethyl acetate/acetone mixed solvent to give the final compound 4CnSAZs (n = 12, 14, 16) as a white solid. The synthetic route of 4CnSAZs (n = 12, 14, 16) is given in the Scheme 1.
Scheme 1.
Synthesis of zwitterionic tetrameric surfactants (4CnSAZs, n = 12, 14, 16).
3.3. Methods
3.3.1. Surface Tension Measurements
The surface tension of 4CnSAZs aqueous solution was measured by QBZY-2 fully automatic surface tensiometer (Shanghai Fangrui Instrument Co., Ltd., Shanghai, China) using the Wilhelmy plate method [42]. The measurements were conducted until the variations in surface tension were less than 0.2 mN m−1 over 5 min. The measurements were carried out at 25 °C, 35 °C, 45 °C, and 55 °C. The averages were obtained by three-run measurements.
3.3.2. Steady-State Fluorescence Spectrum
Fluorescence measurements were conducted with LS-55 fluorescence spectrometer (Perkin-Elmer, Waltham, MA, USA). Under excitation, recording the spectrum between 340 nm and 440 nm with an excitation wavelength of 335 nm, where the concentration of pyrene in each solution is 1 × 10−6 mol L−1. The fluorescence intensity ratio I1/I3 of the first (373 nm) and third (384 nm) vibration peaks depends on the environment of the pyrene molecule. When the ratio of I1/I3 decreases, the environment of pyrene becomes more hydrophobic [63].
3.3.3. Dynamic Light Scattering (DLS)
DLS measurements were performed with a spectrometer (Zetasizer Nano ZS90, Malvern Instruments Ltd., Malvern, UK) to study the aggregation behaviors of 4CnSAZs molecules in aqueous solution. The scattering angle is 90°, and 4CnSAZs solution was filtered through a 0.45 mm membrane filter to remove any interfering dust particles [72]. All measurements were carried out three times at room temperature.
3.3.4. Antibacterial Activities
The plate counting method is a common antibacterial evaluation method that can clearly reflect the antibacterial performance of a compound from a quantitative perspective. The smaller the number of growing colonies, the better the antibacterial effect [73].
The antibacterial activities of 4CnSAZs against two different bacteria: Gram-positive bacterium (S. aureus CMCC 26003) and Gram-negative bacterium (E. coli CMCC 44102) were performed by plate count method [64]. The standardized inoculum was prepared with tryptone (10 g), yeast extract (5 g), NaCl (10 g) and agar (10 g) in 1000 mL of water, and its pH value was adjusted to 7. The two bacteria were cultured in the inoculum at 37 °C until their concentration arrived at 5.0 × 106 CFU/mL before the test. The needed surfactant solution was prepared by adding of 4CnSAZs into autoclaved water and making its concentration 5 g/L.
1.0 mL of the sterilized 4CnSAZs solution was added to 9 mL of the nutrient broths containing the two bacterial strains and deionized water, respectively 0.5 mL of the above three solutions was applied to the eight culture dishes containing the standardized inoculum and then were incubated for 24 h at 37 °C. The number of surviving bacterial colonies was counted and the antibacterial rate was calculated in terms of Formula (13). All the experiments were tested three times, and the glassware used in the experiments was sterilized in an autoclave.
Which, is the antibacterial rate, A is the number of the bacterial colony in the contrast group, and B is the number of bacterial colonies in the experiment group.
3.3.5. Emulsion Stability Measurements
The emulsification ability of 4CnSAZs was assessed by the water-separation-time method [69]. First, 20 mL of 4CnSAZs (0.5 wt%) aqueous solution was added to the stoppered graduated cylinder, and then the same volume of oil phase (n-hexane, kerosene, and liquid paraffin). The cylinder was vigorously shaken up and down 5 times, and then stood for 1 min. The above steps were repeated five times, and the time to separate 10 mL water was recorded. The measurements were made at room temperature, and the average values were recorded three times.
The polarizing microscope (ZEISS Axio Lab.A1) was used to more truly present the emulsion state. 20 mL of kerosene and 80 mL of 4CnSAZs (0.5 wt%) aqueous solution was blended with the digital display high-speed dispersing homogenizer (FJ200-SH, Shanghai Huxi Industry Co., Ltd., Shanghai, China) at a speed of 3000 rpm for 20 min. The appearance of the prepared emulsion was captured to determine the degree of emulsification [74].
4. Conclusions
A series of zwitterionic tetrameric surfactants (4CnSAZs) have been synthesized by a simple and convenient method with commercially available raw materials. 4CnSAZs have better surface activities such as low CAC and γCAC in comparison with conventional surfactants. 4CnSAZs have four alkyl chains closely connected in the single molecule, and the whole molecule is electrically neutral. This structure characteristic of 4CnSAZs can enhance the hydrophobic association among alkyl chains of the same or different molecules and decrease intermolecular electrostatic repulsion, which can result in 4CnSAZs molecules more compact arrangement at air-water interface. The thermodynamic parameters obtained from surface tension measurements at different temperatures show that both the processes of adsorption and micellization of 4CnSAZs are spontaneous and that the micellization processes of 4CnSAZs are entropy driven. The aggregate behavior of 4CnSAZs shows that the alkyl chain length has a greater sensitivity for aggregate growth. The calculated values of critical packing parameters for 4CnSAZs can be supported by the DLS measurements. 4CnSAZs have good emulsification performance, and it is interesting to note that the prepared emulsions appear to exit in the form of multiple emulsions. In addition, 4CnSAZs have good antibacterial activities against E. coli and S. aureus, which are also consistent with the conventional zwitterionic surfactants.
Author Contributions
Conceptualization, X.W., J.L. and X.G.; methodology, X.W., J.L. and C.W.; software, X.W., Y.X. and Z.W.; validation, X.W. and Z.S.; formal analysis, X.W. and D.N.; investigation, X.W., Z.S. and C.W.; data curation, X.W. and Z.W.; writing—original draft preparation, X.W., D.N. and Z.W.; writing—review and editing, X.W., J.L. and X.G.; supervision, J.L. and X.G. All authors have read and agreed to the published version of the manuscript.
Funding
This research received no external funding.
Institutional Review Board Statement
Not applicable.
Informed Consent Statement
Not applicable.
Data Availability Statement
Data is contained within the article.
Acknowledgments
We are also thankful for the support from Yangzhou University for the measurements of antibacterial performance.
Conflicts of Interest
Author Xiangfei Geng was employed by the company China National Petroleum Corporation. Author Di Niu was employed by the company Zhonghao Guangming Research & Design Institute of Chemical Industry Co., Ltd. The remaining authors declare that the research was conducted in the absence of any commercial or financial relationships that could be construed as a potential conflict of interest.
References
- Zhou, M.; Huang, Z.; Yu, S.; Yang, Y.; Huang, Y.S.; Qiu, D.; Zhao, J.Z. Synthesis and surface active properties of novel oligomer betaine surfactants. Tenside Surfactants Deterg. 2016, 53, 134–139. [Google Scholar] [CrossRef]
- Liu, J.H.; Liu, Z.; Yuan, T.J.; Wang, C.W.; Gao, R.M.; Hu, G.F.; Xu, J.S.; Zhao, J.S. Synthesis and properties of zwitterionic gemini surfactants for enhancing oil recovery. J. Mol. Liq. 2020, 311, 113179. [Google Scholar] [CrossRef]
- Yoshimura, T.; Nyuta, K.; Esumi, K. Zwitterionic heterogemini surfactants containing ammonium and carboxylate headgroups. 1. Adsorption and micellization. Langmuir 2005, 21, 2682–2688. [Google Scholar] [CrossRef] [PubMed]
- Kumar, A.; Mandal, A. Synthesis and physiochemical characterization of zwitterionnic surfactant for application in enhanced oil recovery. J. Mol. Liq. 2017, 243, 61–71. [Google Scholar] [CrossRef]
- Yaseen, M.; Wang, Y.; Su, T.J.; Lu, J.R. Surface adsorption of zwitterionic surfactants: N-alkyl phosphocholines characterised by surface tensiometry and neutron reflection. J. Colloid Interface Sci. 2005, 288, 361–370. [Google Scholar] [CrossRef]
- Geng, X.F.; Hu, X.Q.; Jia, X.C.; Luo, L.J. Effects of sodium salicylate on the microstructure of a novel zwitterionic gemini surfactant and its rheological responses. Colloid Polym. Sci. 2014, 292, 915–921. [Google Scholar] [CrossRef]
- Hussain, S.S.; Kamal, M.S.; Fogang, L.T. Synthesis and physicochemical investigation of betaine type polyoxyethylene zwitterionic surfactants containing different ionic headgroups. J. Mol. Struct. 2019, 1178, 83–88. [Google Scholar] [CrossRef]
- Chen, S.Y.; Liu, H.J.; Sun, H.; Yan, X.; Wang, G.H.; Zhou, Y.J.; Zhang, J.N. Synthesis and physiochemical performance evaluation of novel sulphobetaine zwitterionic surfactants from lignin for enhanced oil recovery. J. Mol. Liq. 2018, 249, 73–82. [Google Scholar] [CrossRef]
- Domínguez, R.; Rodríguez, A.; Maestre, A.; Robina, I.; Moyá, M.L. Synthesis and physicochemical characterization of alkanedyil-α-ω-bis (dimethyl dodecylammo-nium) bromide, 12-s-12, 2Br−, surfactants with s= 7, 9, 11 in aqueous medium. J. Colloid Interface Sci. 2012, 386, 228–239. [Google Scholar] [CrossRef]
- Wang, L.Y.; Zhang, Y.; Ding, L.M.; Liu, J.; Zhao, B.; Deng, Q.G.; Yan, T. Synthesis and physiochemical properties of novel gemini surfactants with phenyl-1, 4-bis (carbamoylmethyl) spacer. RSC Adv. 2015, 5, 74764–74773. [Google Scholar] [CrossRef]
- Seredyuk, V.; Alami, E.; Nydén, M.; Holmberg, K.; Peresypkin, A.V.; Menger, F.M. Micellization and adsorption properties of novel zwitterionic surfactants. Langmuir 2001, 17, 5160–5165. [Google Scholar] [CrossRef]
- Morita, T.; Yada, S.; Yoshimura, T. Effect of Spacer Structures on the Interfacial Adsorption and Micelle Properties of Quaternary Ammonium Salt-Based Gemini Surfactants. Langmuir 2021, 38, 156–163. [Google Scholar] [CrossRef] [PubMed]
- Singer, O.M.; Campbell, J.W.; Hoare, J.G.; Masuda, J.D.; Marangoni, G.; Singer, R.D. Improved Green Synthesis and Crystal Structures of Symmetrical Cationic Gemini Surfactants. ACS Omega 2022, 7, 35326–35330. [Google Scholar] [CrossRef] [PubMed]
- Cao, Y.P.; Yang, W.G.; Jiang, Y.J.; Wang, Y.K.; Ju, H.B.; Geng, T. Studies on physicochemical properties of three Gemini surfactants with different spacer groups. J. Mol. Liq. 2021, 325, 115039. [Google Scholar] [CrossRef]
- Yoshimura, T.; Ohno, A.; Esumi, K. Equilibrium and dynamic surface tension properties of partially fluorinated quaternary ammonium salt gemini surfactants. Langmuir 2006, 22, 4643–4648. [Google Scholar] [CrossRef]
- Xing, F.L.; Gao, Y.Y.; Xu, Q.; Li, X.; Wang, L.Y.; Meng, J.; Wang, P.L. The effects of the organic groups attached at the silicone atoms of the organosilane-based Gemini nonionic surfactants on their surface activities. J. Surfactants Deterg. 2014, 17, 739–745. [Google Scholar] [CrossRef]
- Zana, R. Dimeric (gemini) surfactants: Effect of the spacer group on the association behavior in aqueous solution. J. Colloid Interface Sci. 2002, 248, 203–220. [Google Scholar] [CrossRef]
- Knaebel, A.; Oda, R.; Mendesm, E.; Candau, S.J. Lamellar structures in aqueous solutions of a dimeric surfactant. Langmuir 2000, 16, 2489–2494. [Google Scholar] [CrossRef]
- Li, Z.Q.; Zhang, L.; Xu, Z.C.; Liu, D.D.; Song, X.W.; Cao, X.L.; Zhang, L.; Zhao, S. Effect of zwitterionic surfactants on wetting of quartz surfaces. Colloids Surf. A Physicochem. Eng. Asp. 2013, 430, 110–116. [Google Scholar] [CrossRef]
- Mafi, A.; Hu, D.; Chou, K.C. Interactions of sulfobetaine zwitterionic surfactants with water on water surface. Langmuir 2016, 32, 10905–10911. [Google Scholar] [CrossRef]
- Zhou, M.; Li, S.S.; Zhang, Z.; Wang, C.W.; Luo, G.; Zhao, J. Z Progress in the synthesis of zwitterionic gemini surfactants. J. Surfactants Deterg. 2017, 20, 1243–1254. [Google Scholar] [CrossRef]
- Cheng, Y.Q.; Yang, Y.; Niu, C.R.; Feng, Z.; Zhao, W.H.; Lu, S. Progress in synthesis and application of zwitterionic Gemini surfactants. Front. Mater. Sci. 2019, 13, 242–257. [Google Scholar] [CrossRef]
- Xu, W.T.; Han, X.Y.; Fang, B.; He, J.L.; Wu, H.N.; Hui, X. Rheology on novel viscoelastic trimeric octadecyl zwitterionic surfactant micelle solutions. J. Surfactants Deterg. 2023, 26, 667–681. [Google Scholar] [CrossRef]
- Park, K.H.; Lim, J.C. Synthesis of phospholipid based zwitterionic surfactant from coconut oil source and characterization of their interfacial, antiseptic and antiviral propertie. J. Ind. Eng. Chem. 2022, 115, 241–250. [Google Scholar] [CrossRef]
- Yoshimura, T.; Esumi, K. Physicochemical properties of ring-type trimeric surfactants from cyanuric chloride. Langmuir 2003, 19, 3535–3538. [Google Scholar] [CrossRef]
- Murguía, M.C.; Cabrera, M.I.; Guastavino, J.F.; Grau, R.J. New oligomeric surfactants with multiple-ring spacers: Synthesis and tensioactive properties. Colloids Surf. A Physicochem. Eng. Asp. 2005, 262, 1–7. [Google Scholar] [CrossRef]
- In, M.; Bec, V.; Aguerre-Chariol, O.; Zana, R. Quaternary ammonium bromide surfactant oligomers in aqueous solution: Self-association and microstructure. Langmuir 2000, 16, 141–148. [Google Scholar] [CrossRef]
- Zana, R.; Levy, H.; Papoutsi, D.; Beinert, G. Micellization of two triquaternary ammonium surfactants in aqueous solution. Langmuir 1995, 11, 3694–3698. [Google Scholar] [CrossRef]
- In, M.; Warr, G.G.; Zana, R. Dynamics of branched threadlike micelles. Phys. Rev. Lett. 1999, 83, 2278–2281. [Google Scholar] [CrossRef]
- Shi, X.D.; Zeng, M.D.; Xu, X.X.; Liu, Y.X.; Kou, J.J.; Bian, Q.; Song, H.; Zhang, J.J.; Wang, Q.M. Promotion of droplet deposition, diffusion-wetting and retention on hydrophobic surfaces by nonionic star-shaped oligomeric surfactants. J. Mol. Liq. 2023, 386, 122521. [Google Scholar] [CrossRef]
- Menger, F.M.; Migulin, V.A. Synthesis and properties of multiarmed geminis. J. Org. Chem. 1999, 64, 8916–8921. [Google Scholar] [CrossRef]
- Karpichev, Y.; Jahan, N.; Paul, N.; Petropolis, C.P.; Mercer, T.; Grindley, T.B.; Marangoni, D.G. The micellar and surface properties of a unique type of two-headed surfactant–Pentaerythritol based di-cationic surfactants. J. Colloid Interface Sci. 2014, 423, 94–100. [Google Scholar] [CrossRef]
- Jahan, N.; Paul, N.; Petropolis, C.J.; Marangoni, D.G.; Grindley, T.B. Synthesis of surfactants based on pentaerythritol. I. Cationic and zwitterionic gemini surfactants. J. Org. Chem. 2009, 74, 7762–7773. [Google Scholar] [CrossRef]
- Tran, T.; Jahan, N.; Marangoni, D.G.; Grindley, T.B. Synthesis of surfactants based on pentaerythritol. II. Anionic gemini surfactants. Can. J. Chem. 2013, 91, 1085–1092. [Google Scholar] [CrossRef]
- Asadov, Z.G.; Ragimov, R.A.; Akhmedova, G.A. Synthesis, physicochemical characteristics and properties of oligomeric surfactants based on pentaerythritol and propylene oxide. Russ. J. Appl. Chem. 2011, 84, 1188–1194. [Google Scholar] [CrossRef]
- Abdel-Raouf, M.E. Biodegradable polyoxyethylenated pentaerythritol Quaternary esters as oil spill dispersants. Tenside Surfactants Deterg. 2012, 49, 114–123. [Google Scholar] [CrossRef]
- Xie, Y.C.; Li, J.; Li, Z.F.; Sun, T.; Wang, Y.P.; Qu, G.M. The adsorption and aggregation properties of dendritic cationic tetrameric surfactants. RSC Adv. 2018, 8, 36015–36024. [Google Scholar] [CrossRef] [PubMed]
- Gao, B.J.; Yu, Y.M.; Jiang, L.D. Studies on micellar behavior of anionic and surface-active monomers with acrylamide type in aqueous solutions. Colloids Surf. A Physicochem. Eng. Asp. 2007, 293, 210–216. [Google Scholar] [CrossRef]
- Zheng, Y.C.; Lu, X.B.; Lai, L.; Yu, L.W.; Zheng, H.; Dai, C.Y. The micelle thermodynamics and mixed properties of sulfobetaine-type zwitterionic Gemini surfactant with nonionic and anionic surfactants. J. Mol. Liq. 2020, 299, 112108. [Google Scholar] [CrossRef]
- Guo, J.W.; Zhong, X.; Zhu, H.; Feng, L.J.; Cui, Y.D. Synthesis of novel quaternary ammonium surfactants containing adamantane. Chin. Chem. Lett. 2012, 23, 653–656. [Google Scholar] [CrossRef]
- Xie, Y.C.; Li, J.; Sun, T.; Han, Y.; Qu, G.M.; Niu, R.X. Synthesis, surface activity, and corrosion inhibition of dentritic quaternary ammonium salt-type tetrameric surfactants. J. Dispers. Sci. Technol. 2018, 39, 1153–1159. [Google Scholar] [CrossRef]
- Geng, X.F.; Hu, X.Q.; Xia, J.J.; Jia, X.C. Synthesis and surface activities of a novel di-hydroxyl-sulfate-betaine-type zwitterionic gemini surfactants. Appl. Surf. Sci. 2013, 271, 284–290. [Google Scholar] [CrossRef]
- Elged, A.H.; Shaban, S.M.; Eluskkary, M.M.; Aiad, I.; Soliman, E.A.; Elsharif, A.M.; Kim, D.H. Impact of hydrophobic tails of new phospho-zwitterionic surfactants on the structure, catalytic, and biological activities of AgNPs. J. Ind. Eng. Chem. 2021, 94, 435–447. [Google Scholar] [CrossRef]
- Sayed, G.H.; Ghuiba, F.M.; Abdou, M.I.; Badr, E.A.A.; Tawfik, S.M.; Negm, N.A.M. Synthesis, surface, thermodynamic properties of some biodegradable vanillin-modified polyoxyethylene surfactants. J. Surfact. Deterg. 2012, 15, 735–743. [Google Scholar] [CrossRef]
- Shaban, S.M.; Aiad, I.; Ismail, A.R. Surface parameters and biological activity of N-(3-(dimethyl benzyl ammonio) propyl) alkanamide chloride cationic surfactants. J. Surfact. Deterg. 2016, 19, 501–510. [Google Scholar] [CrossRef]
- Zhou, L.M.; Jiang, X.H.; Li, Y.T.; Chen, Z.; Hu, X.Q. Synthesis and properties of a novel class of gemini pyridinium surfactants. Langmuir 2007, 23, 11404–11408. [Google Scholar] [CrossRef]
- Zhang, S.S.; Ding, S.P.; Yu, J.; Chen, X.R.; Lei, Q.F.; Fang, W.J. Antibacterial activity, in vitro cytotoxicity, and cell cycle arrest of gemini quaternary ammonium surfactants. Langmuir 2015, 31, 12161–12169. [Google Scholar] [CrossRef]
- Fu, S.Q.; Guo, J.W.; Zhong, X.; Yang, Z.; Lai, X.F. Synthesis, physiochemical property and antibacterial activity of gemini quaternary ammonium salts with a rigid spacer. RSC Adv. 2016, 6, 16507–16515. [Google Scholar] [CrossRef]
- Zhi, L.F.; Shi, X.F.; Zhang, E.Z.; Pan, Y.L.; Li, X.M.; Wang, H.; Liu, W. Synthesis and properties of stellate lactosamide quaternary ammonium surfactants. Colloids Surf. A Physicochem. Eng. Asp. 2021, 628, 127317. [Google Scholar] [CrossRef]
- Sun, Y.; Han, F.; Zhou, Y.W.; Xu, B.C. Synthesis and properties of quaternary ammonium gemini surfactants with hydroxyethyl at head groups. J. Surfactants Deterg. 2019, 22, 675–681. [Google Scholar] [CrossRef]
- Chauhan, V.; Kumar, M.; Soni, I.; Shandilya, P.; Singh, S. Synthesis, physical properties and cytotoxic assessment of ester-terminated gemini imidazolium surfactants. J. Mol. Liq. 2023, 387, 122645. [Google Scholar] [CrossRef]
- Patial, P.; Shaheen, A.; Ahmad, I. Gemini pyridinium surfactants: Synthesis and their surface active properties. J. Surfactants Deterg. 2014, 17, 929–935. [Google Scholar] [CrossRef]
- Ray, G.B.; Chakraborty, I.; Ghosh, S.; Moulik, S.P.; Palepu, R. Self-aggregation of alkyltrimethylammonium bromides (C10-, C12-, C14-, and C16TAB) and their binary mixtures in aqueous medium: A critical and comprehensive assessment of interfacial behavior and bulk properties with reference to two types of micelle formation. Langmuir 2005, 21, 10958–10967. [Google Scholar] [CrossRef]
- Wang, G.Y.; Li, P.; Du, Z.P.; Wang, W.X.; Li, G.J. Surface activity and aggregation behavior of siloxane-based ionic liquids in aqueous solution. Langmuir 2015, 31, 8235–8242. [Google Scholar] [CrossRef] [PubMed]
- Kamboj, R.; Singh, S.; Chauhan, V. Synthesis, characterization and surface properties of N-(2-hydroxyalkyl)-N′-(2-hydroxyethyl) imidazolium surfactants. Colloids Surf. A Physicochem. Eng. Asp. 2014, 441, 233–241. [Google Scholar] [CrossRef]
- Negm, N.A. Solubilization, surface active and thermodynamic parameters of Gemini amphiphiles bearing nonionic hydrophilic spacers. J. Surfactants Deterg. 2007, 10, 71–80. [Google Scholar] [CrossRef]
- Ren, C.C.; Wang, F.; Zhang, Z.Q.; Nie, H.H.; Li, N.; Cui, M. Synthesis, surface activity and aggregation behavior of Gemini imidazolium surfactants 1, 3-bis (3-alkylimidazolium-1-yl) propane bromide. Colloids Surf. A Physicochem. Eng. Aspects 2015, 467, 1–8. [Google Scholar] [CrossRef]
- Li, B.; Zhang, Q.; Xia, Y.; Gao, Z.N. Surface properties and aggregation behavior of cationic gemini surfactants with dipropylammonium head-groups. Colloids Surf. A Physicochem. Eng. Asp. 2015, 470, 211–217. [Google Scholar] [CrossRef]
- Man, Z.Q.; Wu, W.X. Study on the synthesis, surface activity, and self-assembly behavior of anionic non-ionic gemini surfactants. Molecules 2024, 29, 1725. [Google Scholar] [CrossRef]
- Siddiqui, U.S.; Ghosh, G.; Kabir-ud-Din. Dynamic light scattering studies of additive effects on the microstructure of aqueous gemini micelles. Langmuir 2006, 22, 9874–9878. [Google Scholar] [CrossRef]
- Figueira-Gonzalez, M.; Francisco, V.; Garcia-Rio, L.; Marques, E.F.; Parajo, M.; Rodriguez-Dafonte, P. Self-aggregation properties of ionic liquid 1, 3-didecyl-2-methylimidazolium chloride in aqueous solution: From spheres to cylinders to bilayers. J. Phys. Chem. B 2013, 117, 2926–2937. [Google Scholar] [CrossRef]
- Lu, T.; Han, F.; Mao, G.R.; Lin, G.F.; Huang, J.B.; Huang, X.; Wang, Y.L.; Fu, H.L. Effect of hydrocarbon parts of the polar headgroup on surfactant aggregates in gemini and bola surfactant solutions. Langmuir 2007, 23, 2932–2936. [Google Scholar] [CrossRef] [PubMed]
- Zhang, Q.; Gao, Z.N.; Xu, F.; Tai, S.X.; Liu, X.G.; Mo, S.B.; Niu, F. Surface tension and aggregation properties of novel cationic gemini surfactants with diethylammonium headgroups and a diamido spacer. Langmuir 2012, 28, 11979–11987. [Google Scholar] [CrossRef] [PubMed]
- Taleb, K.; Mohamed-Benkada, M.; Benhamed, N.; Saidi-Besbes, S.; Grohens, Y.; Derdour, A. Benzene ring containing cationic gemini surfactants: Synthesis, surface properties and antibacterial activity. J. Mol. Liq. 2017, 241, 81–90. [Google Scholar] [CrossRef]
- Birnie, C.R.; Malamud, D.; Schnaare, R.L. Antimicrobial evaluation of N-alkyl betaines and N-alkyl-N, N-dimethylamine oxides with variations in chain length. Antimicrob. Agents Chemother. 2000, 44, 2514–2517. [Google Scholar] [CrossRef]
- Wieczorek, D.; Gwiazdowska, D.; Staszak, K.; Chen, Y.L.; Shen, T.L. Surface and antimicrobial activity of sulfobetaines. J. Surfactants Deterg. 2016, 19, 813–822. [Google Scholar] [CrossRef]
- Zhou, Z.C.; Yang, X.Q.; Sun, G.J.; Cheng, Y.M. Study on the synthesis and surface activities of disodium of mono-alkyl polyoxyethylene ether citrate. Tenside Surfactants Deterg. 2007, 44, 287–290. [Google Scholar] [CrossRef]
- Xu, D.Q.; Qi, B.H.; Fang, D.; Zhang, X.M.; Zhang, T. Preparation, characterization and properties of novel cationic gemini surfactants with rigid amido spacer groups. J. Surfactants Deterg. 2016, 19, 91–99. [Google Scholar] [CrossRef]
- Wu, H.R.; Tan, R.; Hong, S.P.; Zhou, Q.; Liu, B.Y.; Chang, J.W.; Luan, T.F.; Kang, N.; Hou, J.R. Synergistic anionic/zwitterionic mixed surfactant system with high emulsification efficiency for enhanced oil recovery in low permeability reservoirs. Petrol Sci. 2024, 21, 936–950. [Google Scholar] [CrossRef]
- Pei, L.J.; Cai, Z.S.; Shang, S.B.; Song, Z.Q. Synthesis and properties of a cationic gemini surfactant with the hydrophenanthrene structure. J. Surfactants Deterg. 2014, 17, 433–439. [Google Scholar] [CrossRef]
- Chen, S.Y.; Li, X.L.; Lei, Q.; Han, Y.H.; Zhou, X.P.; Zhang, J.N. Synthesis, characterization and performance of lignin carboxyl betaine zwitterionic surfactants for application in enhanced oil recovery. RSC Adv. 2023, 13, 16352–16362. [Google Scholar] [CrossRef] [PubMed]
- Dahal, H.; Roy, S.; Dey, J.; Bose Dasgupta, S. Impact of the Hydrocarbon Chain Length of Biodegradable Ester-Bonded Cationic Gemini Surfactants on Self-Assembly, In Vitro Gene Transfection, Cytotoxicity, and Antimicrobial Activity. Langmuir 2024, 40, 2242–2253. [Google Scholar] [CrossRef] [PubMed]
- Richardson, K.E.; Xue, Z.; Huang, Y.; Seo, Y.; Lapitsky, Y. Physicochemical and antibacterial properties of surfactant mixtures with quaternized chitosan microgels. Carb. Pol. 2013, 93, 709–717. [Google Scholar] [CrossRef]
- Sadeghi, M.B.; Ramazani SA, A.; Taghikhani, V.; Ghotbi, C. Experimental investigation of rheological and morphological properties of water in crude oil emulsions stabilized by a lipophilic surfactant. J. Dispers. Sci. Technol. 2013, 34, 356–368. [Google Scholar] [CrossRef]
Disclaimer/Publisher’s Note: The statements, opinions and data contained in all publications are solely those of the individual author(s) and contributor(s) and not of MDPI and/or the editor(s). MDPI and/or the editor(s) disclaim responsibility for any injury to people or property resulting from any ideas, methods, instructions or products referred to in the content. |
© 2024 by the authors. Licensee MDPI, Basel, Switzerland. This article is an open access article distributed under the terms and conditions of the Creative Commons Attribution (CC BY) license (https://creativecommons.org/licenses/by/4.0/).